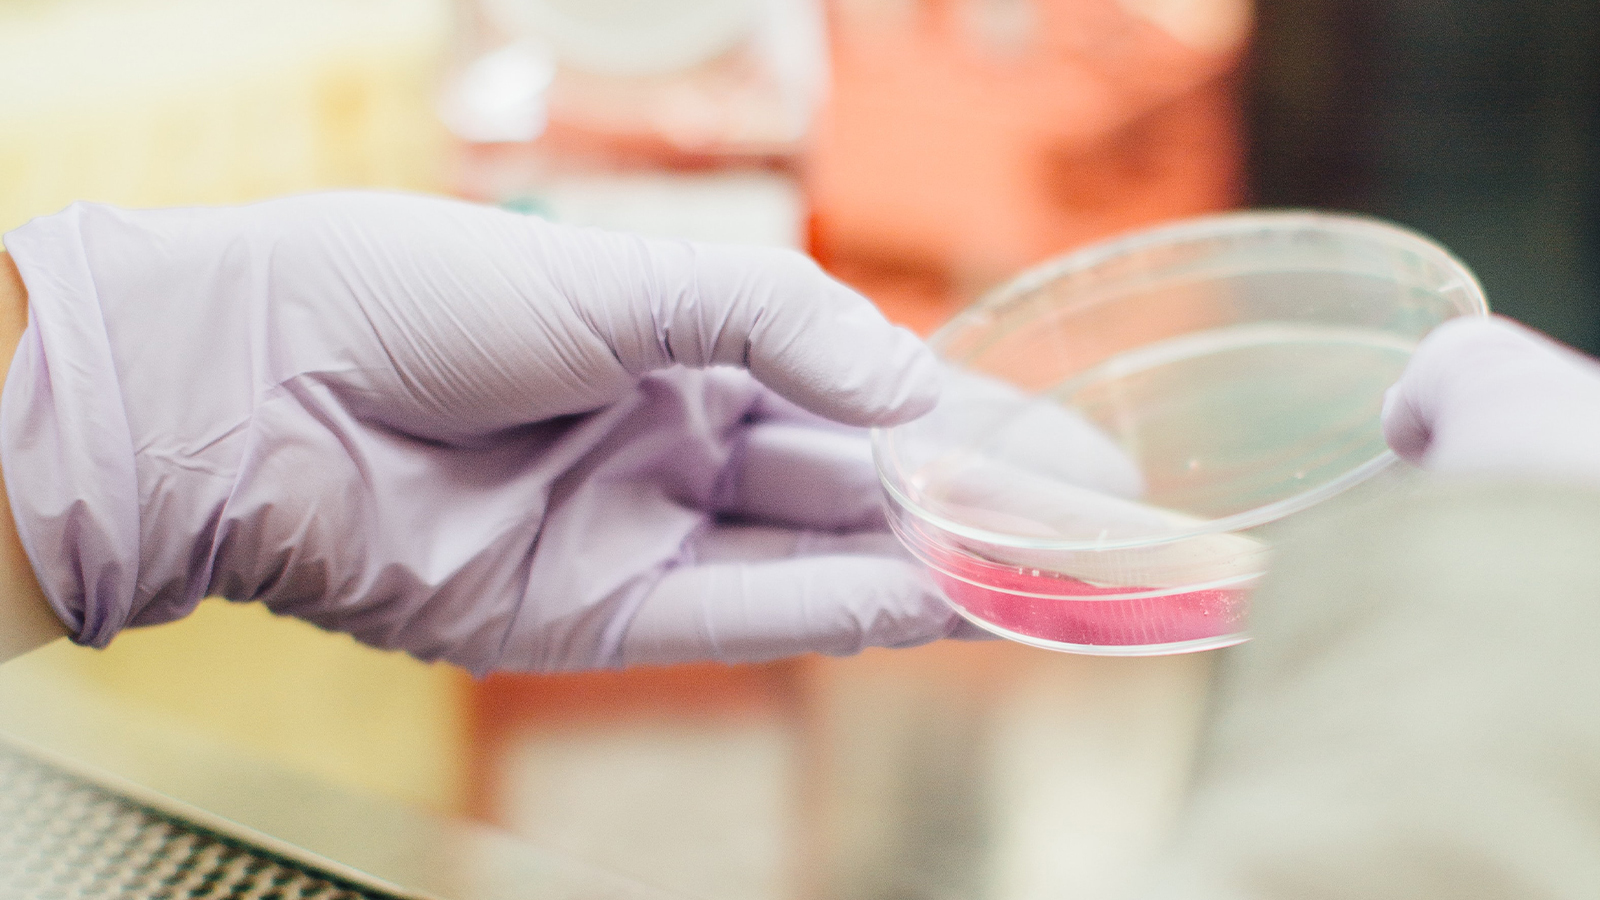

Saama Technologies, based in California, has appointed Neelesh Sali as head of Europe and APAC operations, and managing director of India.
"Neelesh is a proven leader with a track record of success in delivering growth and operational excellence," Vivek Sharma, CEO of Saama Technologies, said. "His appointment reflects our commitment to further strengthen our presence in Europe, APAC and India and serve customers and patients, and we are confident that he will be a valuable asset in helping us achieve our long-term goals."
Neelesh’s new duty is to lead all aspects of the life science solutions provider’s Europe and APAC-based business dealings.
The executive will contribute more than three decades of experience, garnered at Science Group at Clarivate Analytics, where he served as head of the Global Delivery Center, and at DRG India as managing director.
Before that, he worked for Genpact as vice president and service line leader, credited with achieving strong revenue growth in 2017 and 2018.